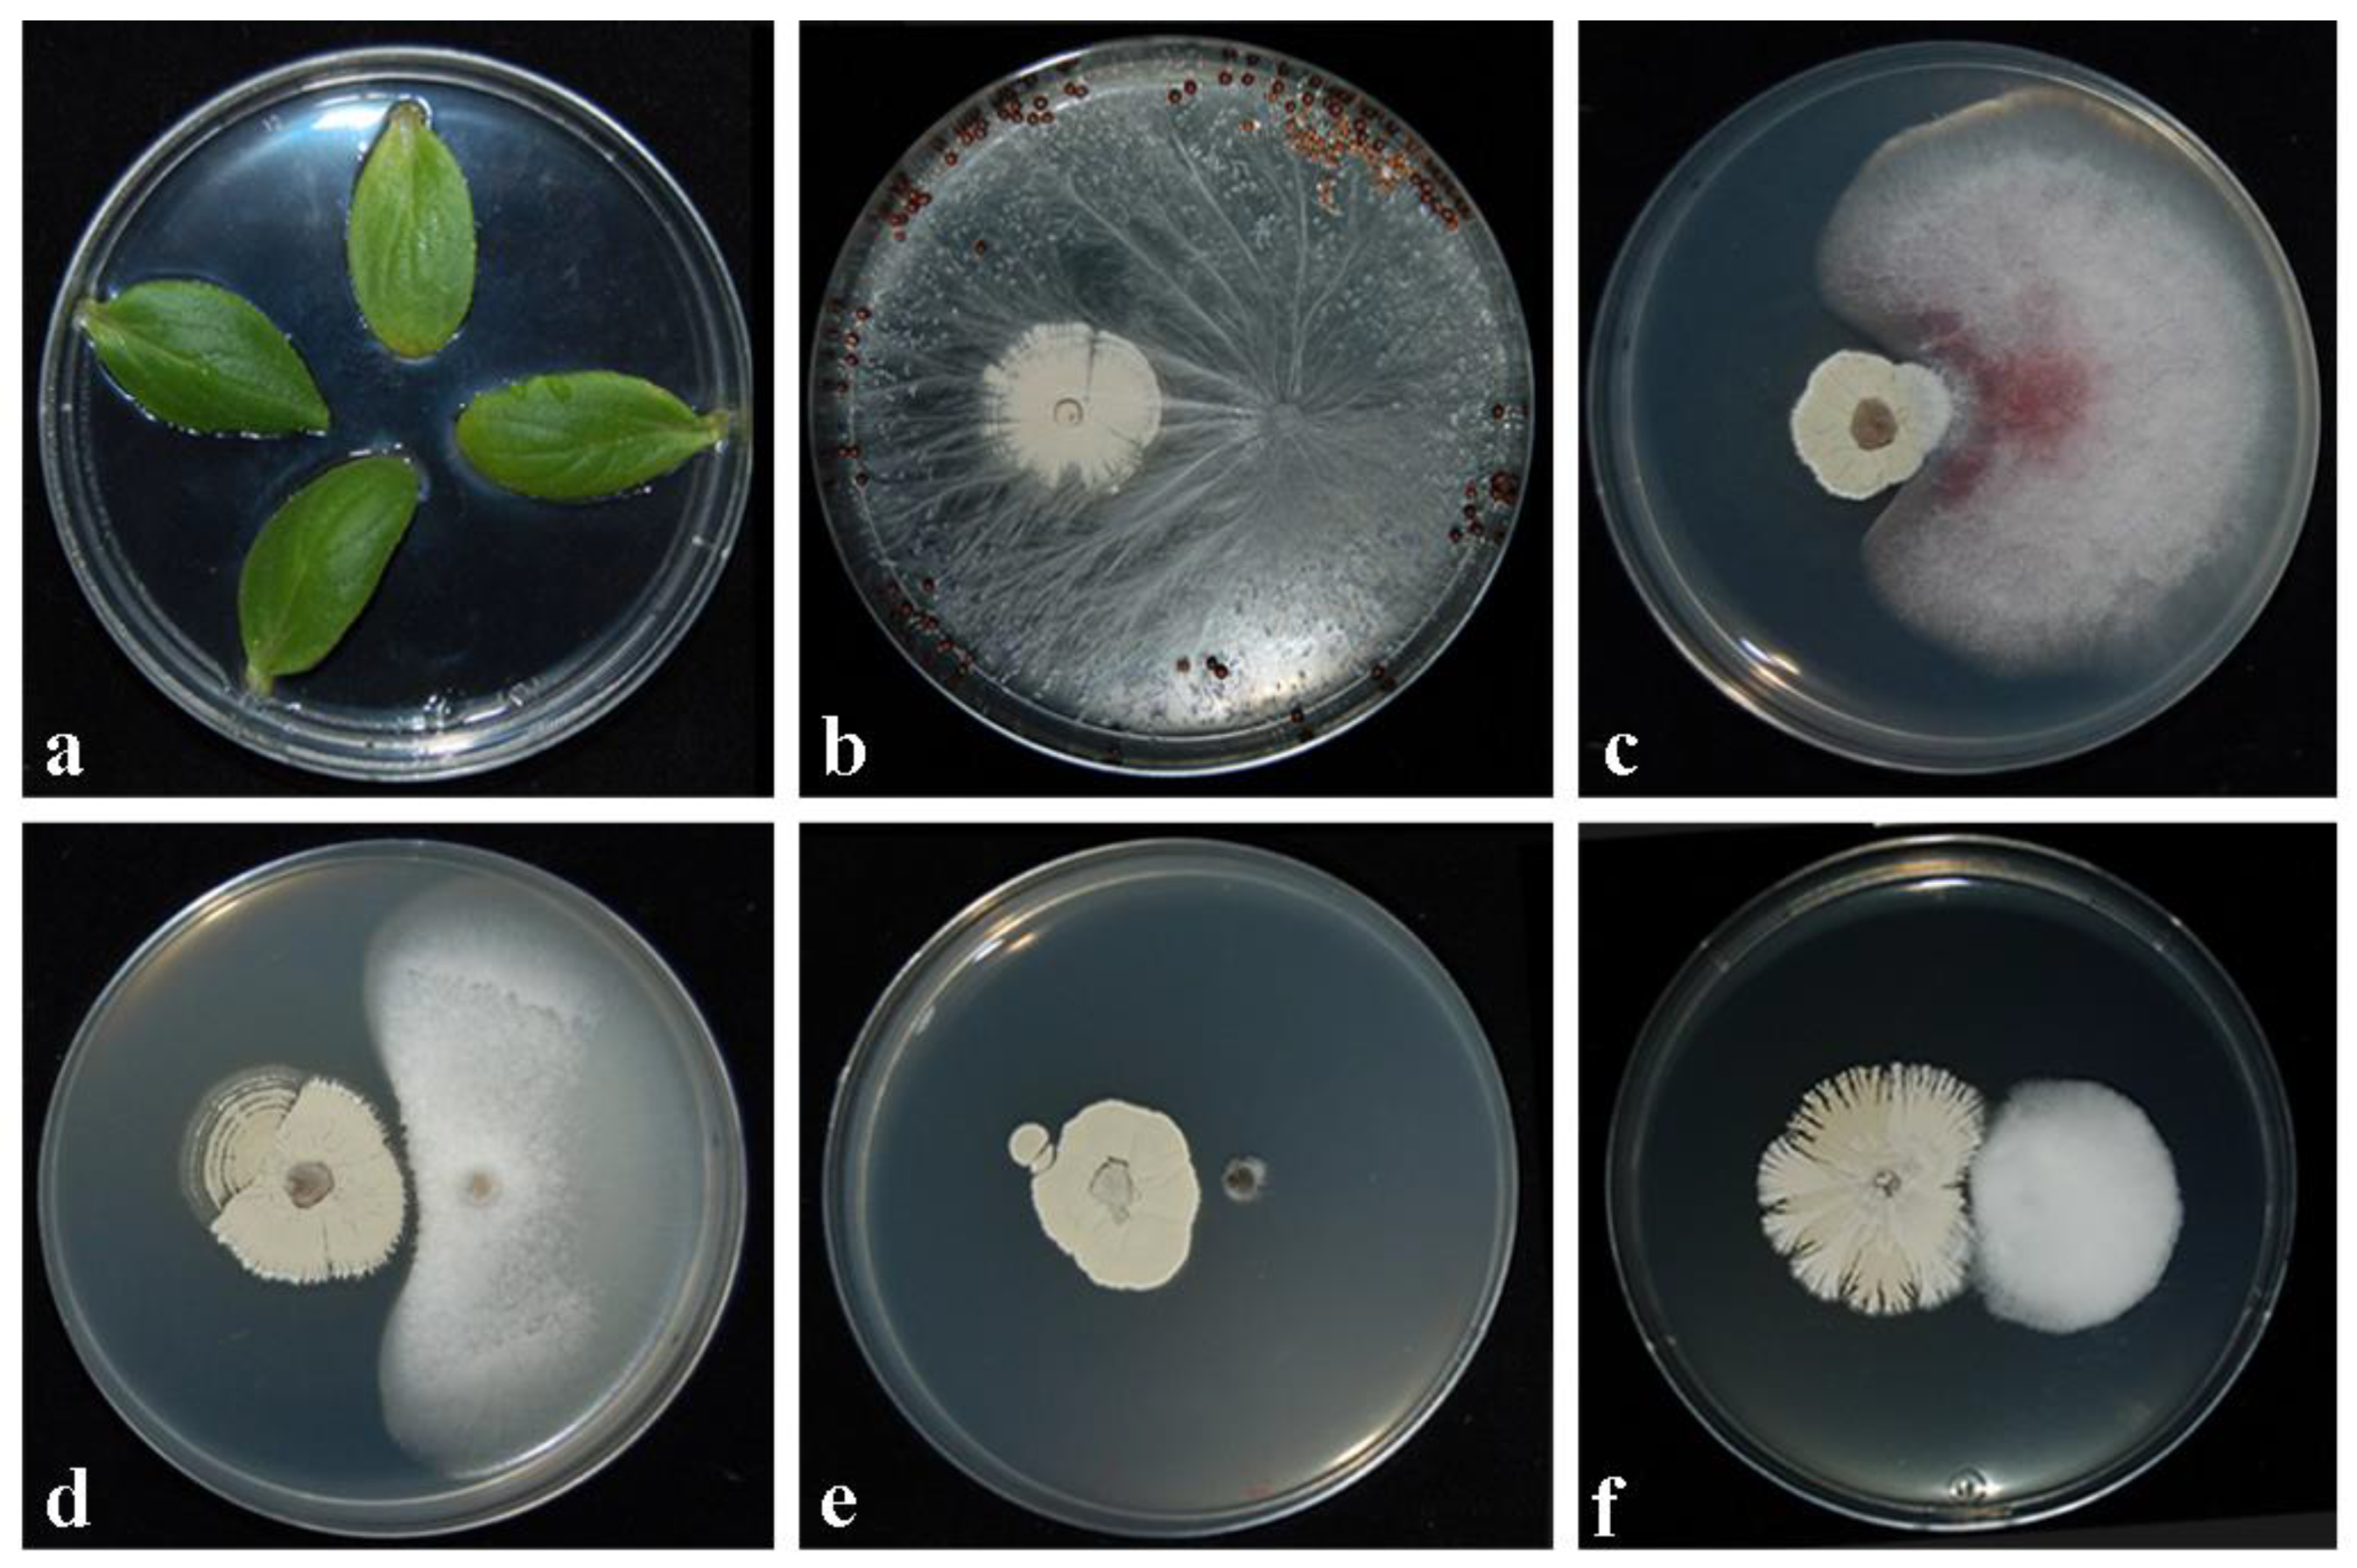
Plants 11 01420 g001

Streptomyces albidoflavus Strain CARA17 as a Biocontrol Agent against Fungal Soil-Borne Pathogens of Fennel Plants
Abstract
1. Introduction
2. Results
2.1. Morphological and Molecular Identification
2.2. Inhibitory Activity against Fungal Pathogens in Dual Cultures
2.3. Assessment of Toxicity/Pathogenicity of CARA17 on Cucumis sativus L. cotyledons In Vitro
2.4. Assessment of Antagonistic Effectiveness of CARA17 Strain on Foeniculum vulgare L. Seedlings against Fungal Soil-Borne Pathogens In Vivo
2.5. Plant Growth Promotion by Streptomyces Strain In Vivo
3. Discussion
4. Materials and Methods
4.1. Isolation and Identification of Actinomycetes Strains
4.2. Fungal Soil-Borne Phytopathogens
4.3. Inhibitory Activity against Fungal Pathogens in Dual Cultures
4.4. Assessment of Toxicity/Pathogenicity of CARA17 Strain on Cucumis sativus L. Cotyledons In Vitro
4.5. Assessment of Antagonistic Effectiveness of CARA17 Strain on Foeniculum vulgare L. Seedlings against Fungal soil-borne pathogens In Vivo
4.6. Plant Growth Promotion by Streptomyces Strain In Vivo
Author Contributions
Funding
Institutional Review Board Statement
Informed Consent Statement
Data Availability Statement
Conflicts of Interest
References
- ISTAT (Istituto Nazionale di Statistica). Ortive: Finocchio in Pien’aria. 2021. Available online: http://dati.istat. (accessed on 17 May 2022).
- Shaker, G.A.; Alhamadany, H.S. Isolation and identification of fungi which infect fennel Foeniculum vulgare Mill. and its impact as antifungal agent. Bull. Iraq nat. Hist. Mus. 2015, 13, 31–38. [Google Scholar]
- Choi, I.Y.; Kim, J.H.; Kim, B.S.; Park, M.J.; Shin, H.D. First report of Sclerotinia stem rot of fennel caused by Sclerotinia sclerotiorum in Korea. Plant Dis. 2016, 100, 223. [Google Scholar] [CrossRef]
- Khare, M.N.; Tiwari, S.P.; Sharma, Y.K. Disease problems in fennel (Foeniculum vulgare Mill) and fenugreek (Trigonella foenum graceum L.) cultivation and their management for production of quality pathogen free seeds. Int. J. Seed Spices 2014, 4, 11–17. [Google Scholar]
- Ghoneem, K.M.; Saber, W.A.; Elwakil, M.A. Alkaline seed bed an innovative technique for manifesting Verticillium dahliae on fennel seeds. Plant Pathol. J. 2009, 8, 22–26. [Google Scholar] [CrossRef]
- Dias, M.C. Phytotoxicity: An overview of the physiological responses of plants exposed to fungicides. J. Bot. 2012, 2012, 135479. [Google Scholar] [CrossRef]
- Chilosi, G.; Aleandri, M.A.; Luccioli, E.; Stazi, S.R.; Marabottini, R.; Morales-Rodríguez, C.; Vettraino, A.N.; Vannini, A. Suppression of soil-borne plant pathogens in growing media amended with espresso spent coffee grounds as a carrier of Trichoderma spp. Sci. Hortic. 2020, 259, 108666. [Google Scholar] [CrossRef]
- Kowalska, B.; Smolińska, U.; Szczech, M.; Winciorek, J. Application of organic waste material overgrown with Trichoderma atroviride as a control strategy for Sclerotinia sclerotiorum and Chalara thielavioides in soil. J. Plant Prot. Res. 2017, 57, 205–211. [Google Scholar] [CrossRef][Green Version]
- Oktay, E.; Kemal, B. Biological control of Verticillium wilt on cotton by the use of fluorescent Pseudomonas spp. under field conditions. Biol. Control. 2010, 53, 39–45. [Google Scholar]
- Khan, M.; Salman, M.; Jan, S.A.; Shinwari, Z.K. Biological control of fungal phytopathogens: A comprehensive review based on Bacillus species. MOJ Biol. Med. 2021, 6, 90–92. [Google Scholar] [CrossRef]
- Basu, A.; Prasad, P.; Das, S.N.; Kalam, S.; Sayyed, R.Z.; Reddy, M.S.; El Enshasy, H. Plant Growth Promoting Rhizobacteria (PGPR) as Green Bioinoculants: Recent Developments, Constraints, and Prospects. Sustainability 2021, 13, 1140. [Google Scholar] [CrossRef]
- Comasriu, J.; Vivesrego, J. Cytometric monitoring of growth, sporogenesis and spore cell sorting in Paenibacillus polymyxa (formerly Bacillus polymyxa). J. Appl. Microbiol. 2002, 92, 475–481. [Google Scholar] [CrossRef] [PubMed]
- Emmert, E.A.; Handelsman, J. Biocontrol of plant disease: A (gram-) positive perspective. FEMS Microbiol. Lett. 1999, 171, 1–9. [Google Scholar] [CrossRef] [PubMed]
- Seipke, R.F.; Kaltenpoth, M.; Hutchings, M.I. Streptomyces as symbionts: An emerging and widespread theme? FEMS Microbiol. Rev. 2012, 36, 862–876. [Google Scholar] [CrossRef] [PubMed]
- Colombo, E.M.; Kunova, A.; Pizzatti, C.; Saracchi, M.; Cortesi, P.; Pasquali, M. Selection of an endophytic Streptomyces sp. strain DEF09 from wheat roots as a biocontrol agent against Fusarium graminearum. Front. Microbiol. 2019, 10, 2356. [Google Scholar] [CrossRef]
- Liu, D.; Yan, R.; Fu, Y.; Wang, X.; Zhang, J.; Xiang, W. Antifungal, plant growth-promoting, and genomic properties of an endophytic actinobacterium Streptomyces sp. NEAU-S7GS2. Front. Microbiol. 2019, 10, 2077. [Google Scholar] [CrossRef] [PubMed]
- Boukaew, S.; Prasertsan, P. Suppression of rice sheath blight disease using a heat stable culture filtrate from Streptomyces philanthi RM-1-138. Crop Prot. 2014, 61, 1–10. [Google Scholar] [CrossRef]
- Kunova, A.; Cortesi, P.; Saracchi, M.; Migdal, G.; Pasquali, M. Draft genome sequences of two Streptomyces albidoflavus strains DEF1AK and DEF147AK with plant growth promoting and biocontrol potential. Ann. Microbiol. 2021, 71, 2–8. [Google Scholar] [CrossRef]
- Hartman, A.; Schmid, M.; van Tuinen, D.; Berg, G. Plant driven selection of microbes. Plant Soil 2009, 321, 235–257. [Google Scholar] [CrossRef]
- Faheem, M.; Raza, W.; Zhong, W.; Nan, Z.; Shen, Q.; Xu, Y. Evaluation of the biocontrol potential of Streptomyces goshikiensis YCXU against Fusarium oxysporum f. sp. niveum. Biol. Control 2015, 81, 101–110. [Google Scholar] [CrossRef]
- Kaur, T.; Rani, R.; Manhas, R.K. Biocontrol and plant growth promoting potential of phylogenetically new Streptomyces sp. MR14 of rhizospheric origin. AMB Express 2019, 9, 125. [Google Scholar] [CrossRef]
- Law, J.W.F.; Ser, H.L.; Khan, T.M.; Chuah, L.H.; Pusparajah, P.; Chan, K.G.; Goh, B.H.; Lee, L.H. The Potential of Streptomyces as Biocontrol Agents against the Rice Blast Fungus, Magnaporthe oryzae (Pyricularia oryzae). Front. Microbiol. 2017, 8, 3. [Google Scholar] [CrossRef] [PubMed]
- De-Oliveira, M.F.; Da Silva, M.G.; Van Der Sand, S.T. Anti-phytopathogen potential of endophytic actinobacteria isolated from tomato plants (Lycopersicon esculentum) in southern Brazil, and characterization of Streptomyces sp. R18, a potential biocontrol agent. Res. Microbiol. 2010, 161, 565–572. [Google Scholar] [CrossRef] [PubMed]
- Passari, A.K.; Mishra, V.K.; Gupta, V.K.; Yadav, M.K.; Saikia, R.; Singh, B.P. In vitro and in vivo plant-growth-promoting activities and DNA fingerprinting of antagonistic endophytic actinomycetes associates with medicinal plants. PLoS ONE 2015, 10, 0139468. [Google Scholar] [CrossRef]
- Etesami, H.; Maheshwar, D.K. Use of plant growth promoting rhizobacteria (PGPRs) with multiple plant growth promoting traits in stress agriculture: Action mechanisms and future prospects. Ecotoxicol. Environ. Safe. 2018, 156, 225–246. [Google Scholar] [CrossRef] [PubMed]
- Raimondo, M.L.; Carlucci, A. Characterization and pathogenicity assessment of Plectosphaerella species associated with stunting disease on tomato and pepper crops in Italy. Plant Pathol. 2018, 67, 626–641. [Google Scholar] [CrossRef]
- Raimondo, M.L.; Carlucci, A. Characterization and pathogenicity of Plectosphaerella spp. collected from basil and parsley in Italy. Phytopathol. Mediterr. 2018, 57, 284–295. [Google Scholar]
- Carlucci, A.; Lops, F.; Mostert, L.; Halleen, F.; Raimondo, M.L. Occurrence fungi causing black foot on young grapevines and nursery rootstock plants in Italy. Phytopathol. Mediterr. 2017, 56, 10–39. [Google Scholar]
- Carlucci, A.; Raimondo, M.L.; Cibelli, F.; Phillips, A.J.L.; Lops, F. Pleurostomophora richardsiae, Neofusicoccum parvum and Phaeoacremonium aleophilum associated with a decline of olives in southern Italy. Phytopathol. Mediterr. 2013, 52, 517–527. [Google Scholar]
- Shariffah-Muzaimah, S.A.; Idris, A.S.; Madihah, A.Z.; Dzolkhifli, O.; Kamaruzzaman, S.; Maizatul-Suriza, M. Characterization of Streptomyces spp. isolated from the rhizosphere of oil palm and evaluation of their ability to suppress basal stem rot disease in oil palm seedlings when applied as powder formulations in a glasshouse trial. World J. Microb. Biot. 2018, 34, 15. [Google Scholar] [CrossRef]
- Meyer, W.; Mitchell, T.G.; Freedman, E.Z.; Vilgalys, R. Hybridization probes for conventional DNA fingerprinting used as single primers in the polymerase chain reaction to distinguish strains of Cryptococcus neoformans. J. Clin. Microbiol. 1993, 31, 2274–2280. [Google Scholar] [CrossRef]
- Santos, J.M.; Phillips, A.J.L. Resolving the complex of Diaporthe (Phomopsis) species occurring on Foeniculum vulgare in Portugal. Fungal Divers. 2009, 34, 111–125. [Google Scholar]
- Carlucci, A.; Raimondo, M.L.; Santos, J.; Phillips, A.J.L. Plectosphaerella species associated with root and collar rots of horticultural crops in southern Italy. Persoonia 2012, 28, 34–48. [Google Scholar] [CrossRef] [PubMed]
- Kunova, A.; Bonaldi, M.; Saracchi, M.; Pizzatti, C.; Chen, X.; Cortesi, P. Selection of Streptomyces against soil borne fungal pathogens by a standardized dual culture assay and evaluation of their effects on seed germination and plant growth. BMC Microbiol. 2016, 16, 272. [Google Scholar] [CrossRef] [PubMed]

| Inibition Activity (IA) % | ||||||
|---|---|---|---|---|---|---|
| Fungal Soilborne Isolates | 14 Days a | 21 Days | 28 Days | |||
| Mean | Min–Max c | Mean | Min–Max | Mean | Min–Max | |
| Athelia rolfsii | 15.08 D b | 14.92–15.25 | 4.31 D | 4.12–4.50 | 0.00 D | 0.00–0.00 |
| Verticillium dahliae | 87.42 C | 86.31–86.54 | 77.15 BC | 76.96–77.34 | 71.30 C | 71.28–71.32 |
| Plectosphaerella ramiseptata | 96.35 B | 96.33–96.74 | 84.82 B | 84.58–85.07 | 82.73 B | 82.27–83.19 |
| Fusarium oxysporum | 88.26 D | 88.63–87.89 | 84.91 B | 82.32–87.50 | 84.71 B | 80.82–88.60 |
| Sclerotinia sclerotiorum | 100.00 A | 100.00–100.00 | 100.00 A | 100.00–100.00 | 100.00 A | 100.00–100.00 |
| Description Symptoms Recodered | |||||||
|---|---|---|---|---|---|---|---|
| Treatment with CARA17 Strain | Fungal Pathogen | Root | DS | Leaves | DS | Re-Isolation from Root (%) | |
| TEST 1 | Dipping | Athelia rolfsii | No disease symptoms | 0.0 | No disease symptoms | 0.0 | 13.3 |
| Dipping | Fusarium oxysporum | Light root browning | 0.9 | Light growth reduction and yellowing | 0.6 | 13.3 | |
| Dipping | Plectosphaerella ramiseptata | Light root growth reduction | 0.6 | Light apical yellowing | 0.4 | 13.3 | |
| Dipping | Sclerotinia sclerotiorum | No disease symptoms | 0.0 | No disease symptoms | 0.0 | 13.3 | |
| Dipping | Verticillium dahliae | Light root growth reduction | 0.8 | Light growth reduction | 0.7 | 26.6 | |
| Dipping | No fungal pathogen | No disease symptoms | 0.0 | No disease symptoms | 0.0 | - | |
| TEST 2 | After transplanting | Athelia rolfsii | No disease symptoms | 0.0 | No disease symptoms | 0.0 | 26.6 |
| After transplanting | Fusarium oxysporum | Root growth reduction | 1.9 | Growth reduction and yellowing | 1.2 | 40.0 | |
| After transplanting | Plectosphaerella ramiseptata | Root browning | 1.9 | Growth reduction and yellowing | 1.5 | 86.6 | |
| After transplanting | Sclerotinia sclerotiorum | Light root growth reduction | 0.6 | No disease symptoms | 0.0 | 33.3 | |
| After transplanting | Verticillium dahliae | Root growth reduction | 1.8 | Growth reduction | 1.8 | 80.0 | |
| After transplanting | No fungal pathogen | No disease symptoms | 0.0 | No disease symptoms | 0.0 | - | |
| No treatment | Athelia rolfsii | Root browning and rot | 4.8 | Growth reduction and yellowing | 2.7 | 100.0 | |
| No treatment | Fusarium oxysporum | Root browning | 2.7 | Growth reduction and yellowing | 1.8 | 86.6 | |
| No treatment | Plectosphaerella ramiseptata | Root browning | 2.9 | Growth reduction and yellowing | 1.7 | 93.3 | |
| No treatment | Sclerotinia sclerotiorum | Root browning and rot | 2.1 | Growth reduction | 1.4 | 93.3 | |
| No treatment | Verticillium dahliae | Root growth reduction | 2.3 | Growth reduction | 1.5 | 80.0 | |
| Control | No fungal pathogen | No disease symptoms | 0.0 | No disease symptoms | 0.0 | - | |
| Growth Promotion by Biomass * (gr) | ||||||
|---|---|---|---|---|---|---|
| Fresh | Dry | |||||
| Treatment with CARA17 Strain | Fungal Pathogen | Mean ** | SD § | Mean | SD | |
| TEST 1 | Dipping | A. rolfsii | 93.11 E † | 5.13 | 11.69 D | 2.64 |
| Dipping | F. oxysporum | 85.07 D | 3.97 | 6.90 B | 0.83 | |
| Dipping | P. ramiseptata | 85.57 D | 4.14 | 7.15 BC | 1.71 | |
| Dipping | S. sclerotiorum | 87.27 D | 7.04 | 8.23 C | 0.92 | |
| Dipping | V. dahliae | 85.15 D | 3.33 | 6.86 B | 0.99 | |
| Dipping | No fungal pathogen | 165.03 H | 15.60 | 14.43 E | 2.47 | |
| TEST 2 | After transplanting | A. rolfsii | 69.95 C | 10.02 | 8.81 C | 2.13 |
| After transplanting | F. oxysporum | 60.05 C | 2.37 | 6.25 B | 0.57 | |
| After transplanting | P. ramiseptata | 45.20 A | 7.00 | 4.93 AB | 0.61 | |
| After transplanting | S. sclerotiorum | 87.27 D | 5.29 | 7.35 BC | 0.99 | |
| After transplanting | V. dahliae | 69.97 C | 11.14 | 6.34 B | 2.16 | |
| After transplanting | No fungal pathogen | 122.86 G | 15.76 | 12.74 DE | 1.74 | |
| No treatment | A. rolfsii | 38.13 A | 5.69 | 4.15 A | 0.34 | |
| No treatment | F. oxysporum | 47.69 AB | 3.69 | 5.09 AB | 0.24 | |
| No treatment | P. ramiseptata | 48.33 AB | 4.56 | 6.03 B | 0.61 | |
| No treatment | S. sclerotiorum | 44.08 A | 4.68 | 4.89 AB | 0.70 | |
| No treatment | V. dahliae | 45.51 A | 6.20 | 5.00 AB | 0.29 | |
| Control | No fungal pathogen | 101.61 F | 7.00 | 11.66 D | 1.61 | |
Publisher’s Note: MDPI stays neutral with regard to jurisdictional claims in published maps and institutional affiliations. |
© 2022 by the authors. Licensee MDPI, Basel, Switzerland. This article is an open access article distributed under the terms and conditions of the Creative Commons Attribution (CC BY) license (https://creativecommons.org/licenses/by/4.0/).
Share and Cite
Carlucci, A.; Raimondo, M.L.; Colucci, D.; Lops, F. Streptomyces albidoflavus Strain CARA17 as a Biocontrol Agent against Fungal Soil-Borne Pathogens of Fennel Plants. Plants 2022, 11, 1420. https://doi.org/10.3390/plants11111420
Carlucci A, Raimondo ML, Colucci D, Lops F. Streptomyces albidoflavus Strain CARA17 as a Biocontrol Agent against Fungal Soil-Borne Pathogens of Fennel Plants. Plants. 2022; 11(11):1420. https://doi.org/10.3390/plants11111420
Chicago/Turabian StyleCarlucci, Antonia, Maria Luisa Raimondo, Donato Colucci, and Francesco Lops. 2022. "Streptomyces albidoflavus Strain CARA17 as a Biocontrol Agent against Fungal Soil-Borne Pathogens of Fennel Plants" Plants 11, no. 11: 1420. https://doi.org/10.3390/plants11111420
APA StyleCarlucci, A., Raimondo, M. L., Colucci, D., & Lops, F. (2022). Streptomyces albidoflavus Strain CARA17 as a Biocontrol Agent against Fungal Soil-Borne Pathogens of Fennel Plants. Plants, 11(11), 1420. https://doi.org/10.3390/plants11111420

